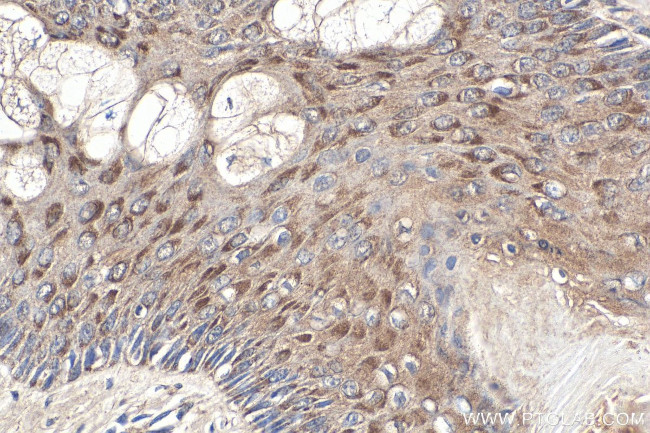
NRAS Antibody in Immunohistochemistry (Paraffin) (IHC (P))

Search
Proteintech
NRAS Polyclonal Antibody
{{$productOrderCtrl.translations['antibody.pdp.commerceCard.promotion.promotions']}}
{{$productOrderCtrl.translations['antibody.pdp.commerceCard.promotion.viewpromo']}}
{{$productOrderCtrl.translations['antibody.pdp.commerceCard.promotion.promocode']}}: {{promo.promoCode}} {{promo.promoTitle}} {{promo.promoDescription}}. {{$productOrderCtrl.translations['antibody.pdp.commerceCard.promotion.learnmore']}}
图: 1 / 17
NRAS Antibody (18296-1-AP150UL) in IHC (P)

















产品信息
18296-1-AP150UL
种属反应
宿主/亚型
分类
类型
偶联物
形式
浓度
规格
纯化类型
保存液
内含物
保存条件
运输条件
靶标信息
NRAS (GTPase NRas) is a membrane protein that shuttles between the Golgi apparatus and the plasma membrane. This shuttling is regulated through palmitoylation and depalmitoylation by the ZDHHC9-GOLGA7 complex. This protein, which has intrinsic GTPase activity, is activated to a GTP-bound form by a GTPase activating protein and inactivated to a GDP-bound form by a guanine nucleotide-exchange factor. Defects in the gene encoding this protein are a cause of juvenile myelomonocytic leukemia (JMML) and Noonan syndrome 6.
仅用于科研。不用于诊断过程。未经明确授权不得转售。
篇参考文献 (0)
生物信息学
蛋白别名: GTPase NRas; N-ras protein part 4; Neuroblastoma RAS; neuroblastoma RAS viral (v-ras) oncogene homolog; neuroblastoma RAS viral oncogene homolog; proto-oncogene GTPase; RAS; RASN; small GTP binding protein; Transforming protein N-Ras; unnamed protein product; v-ras neuroblastoma RAS viral oncogene homolog
基因别名: ALPS4; CMNS; HRAS1; KRAS; N-ras; NCMS; NRAS; NRAS1; NS6
UniProt ID: (Human) P01111, (Rat) Q04970
Entrez Gene ID: (Human) 4893, (Rat) 24605